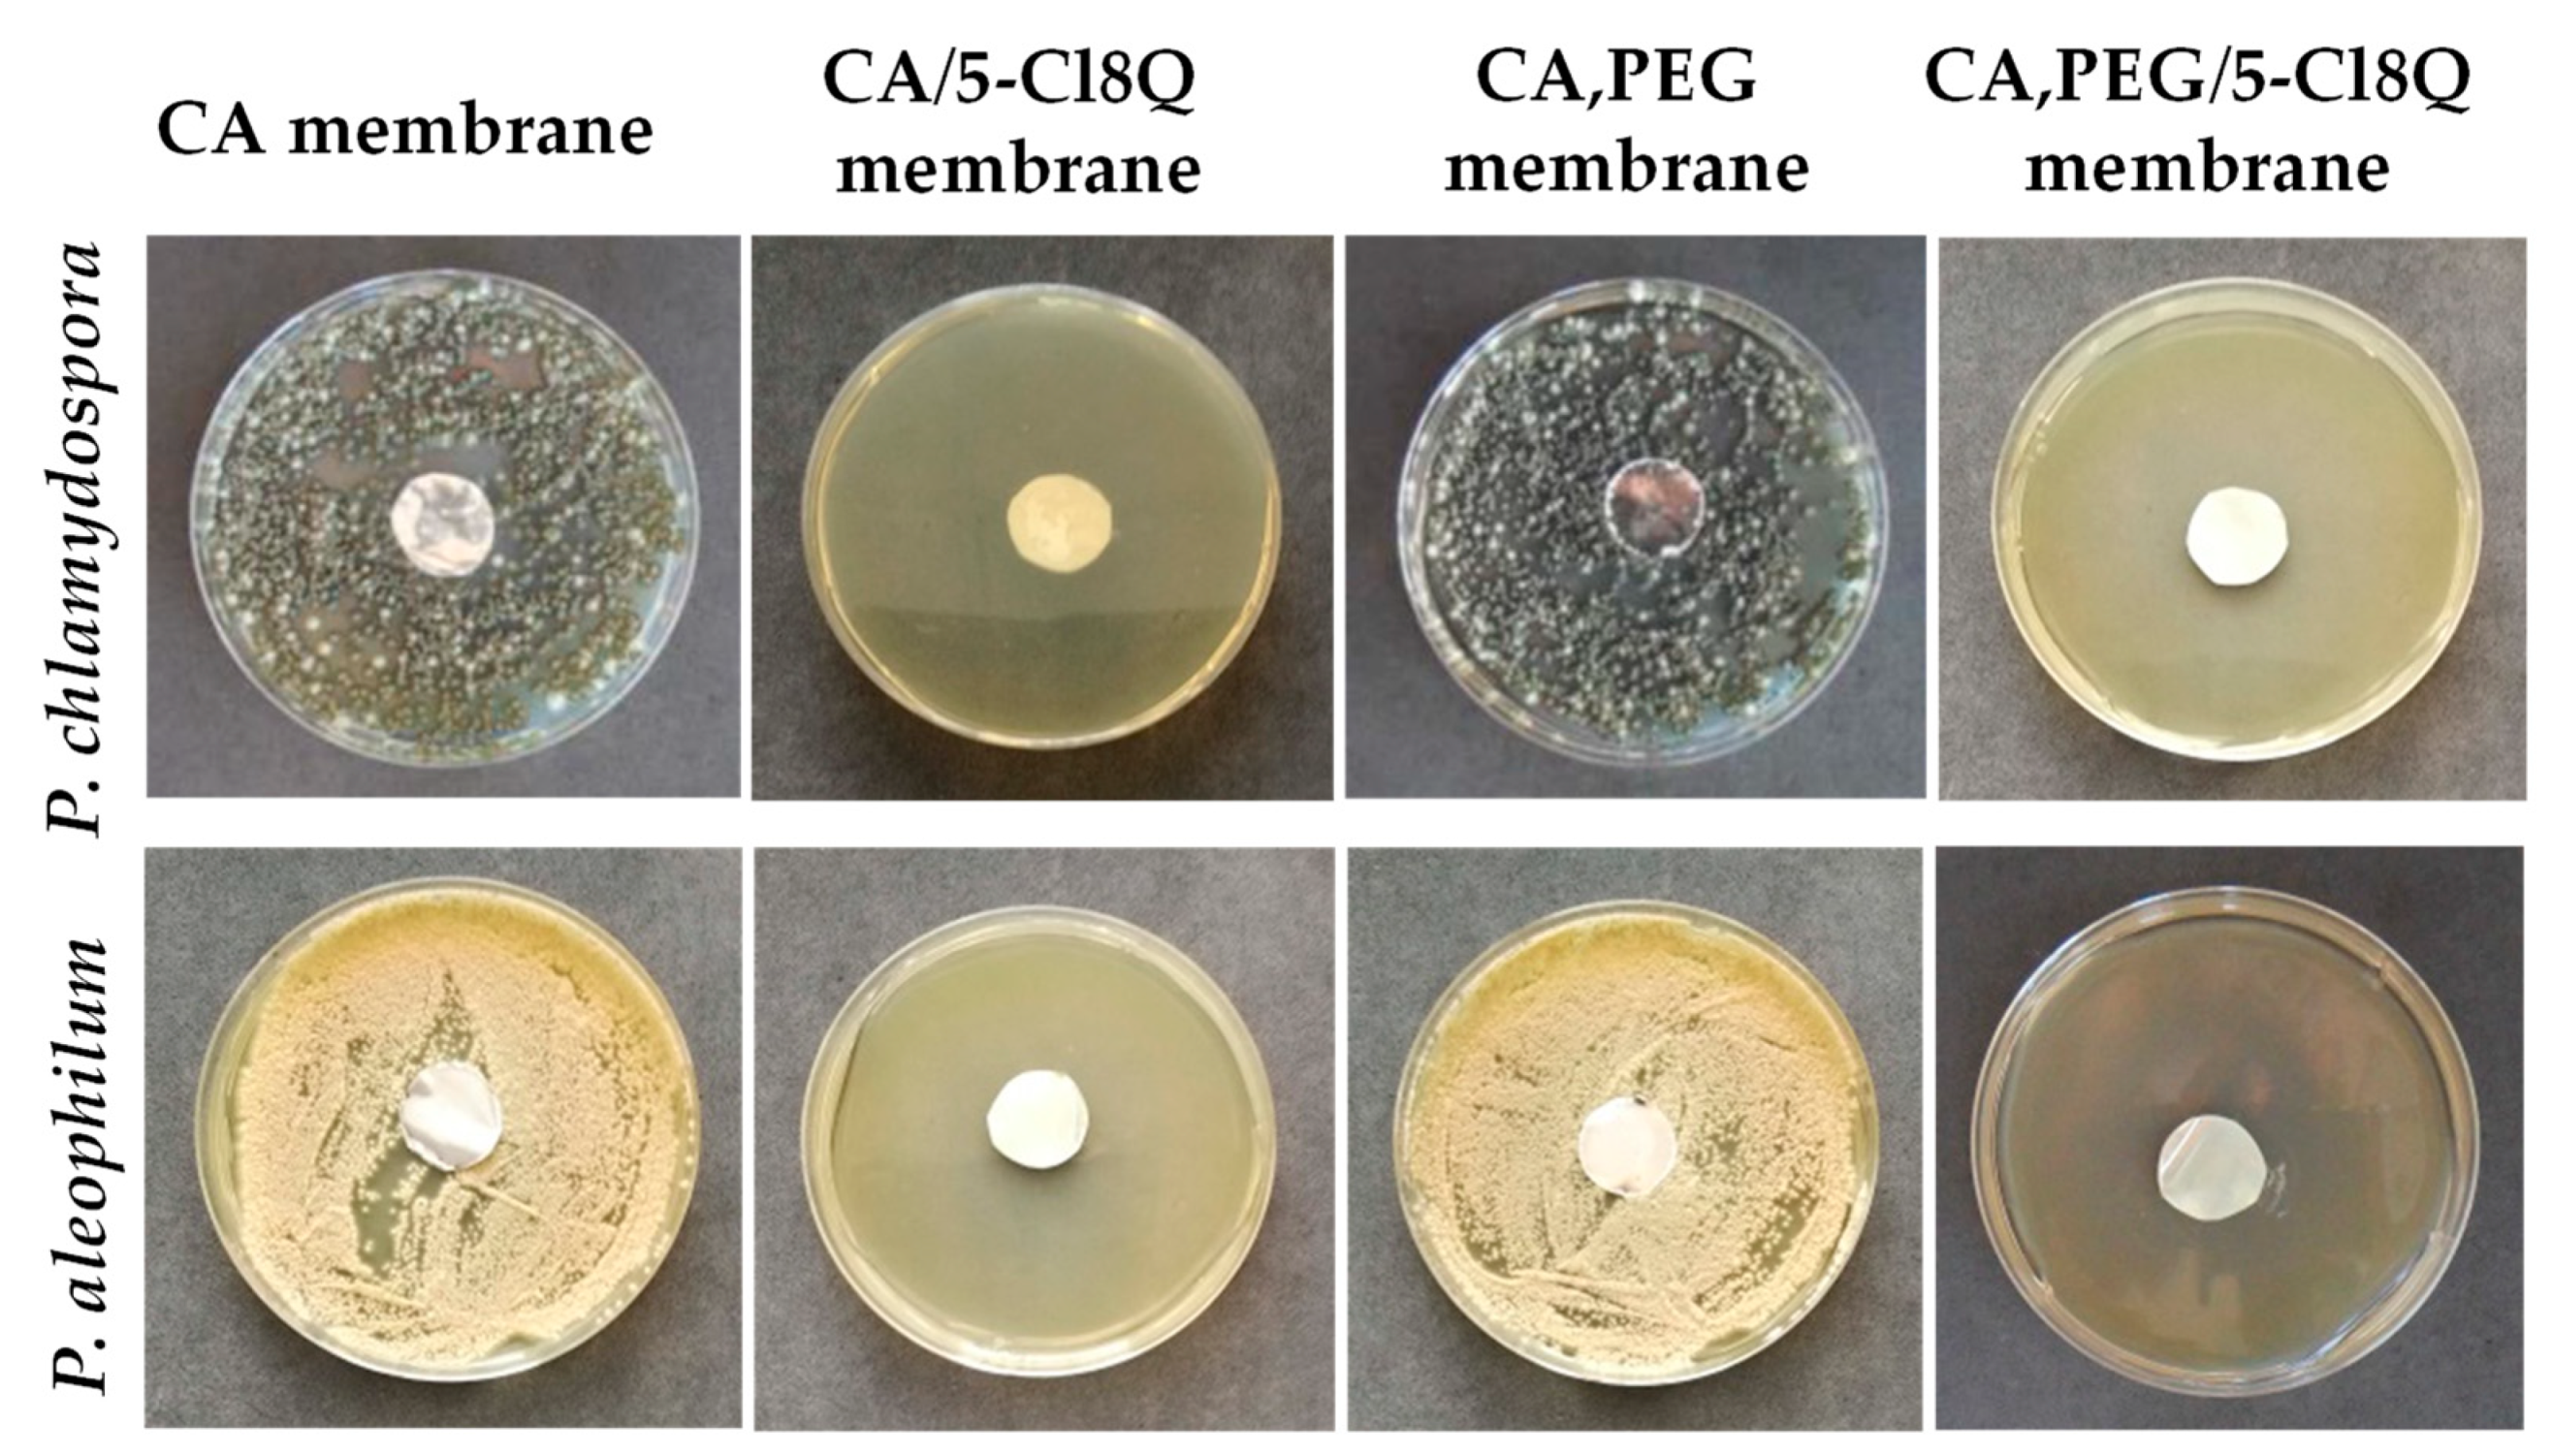
Molecules 27 05738 g001
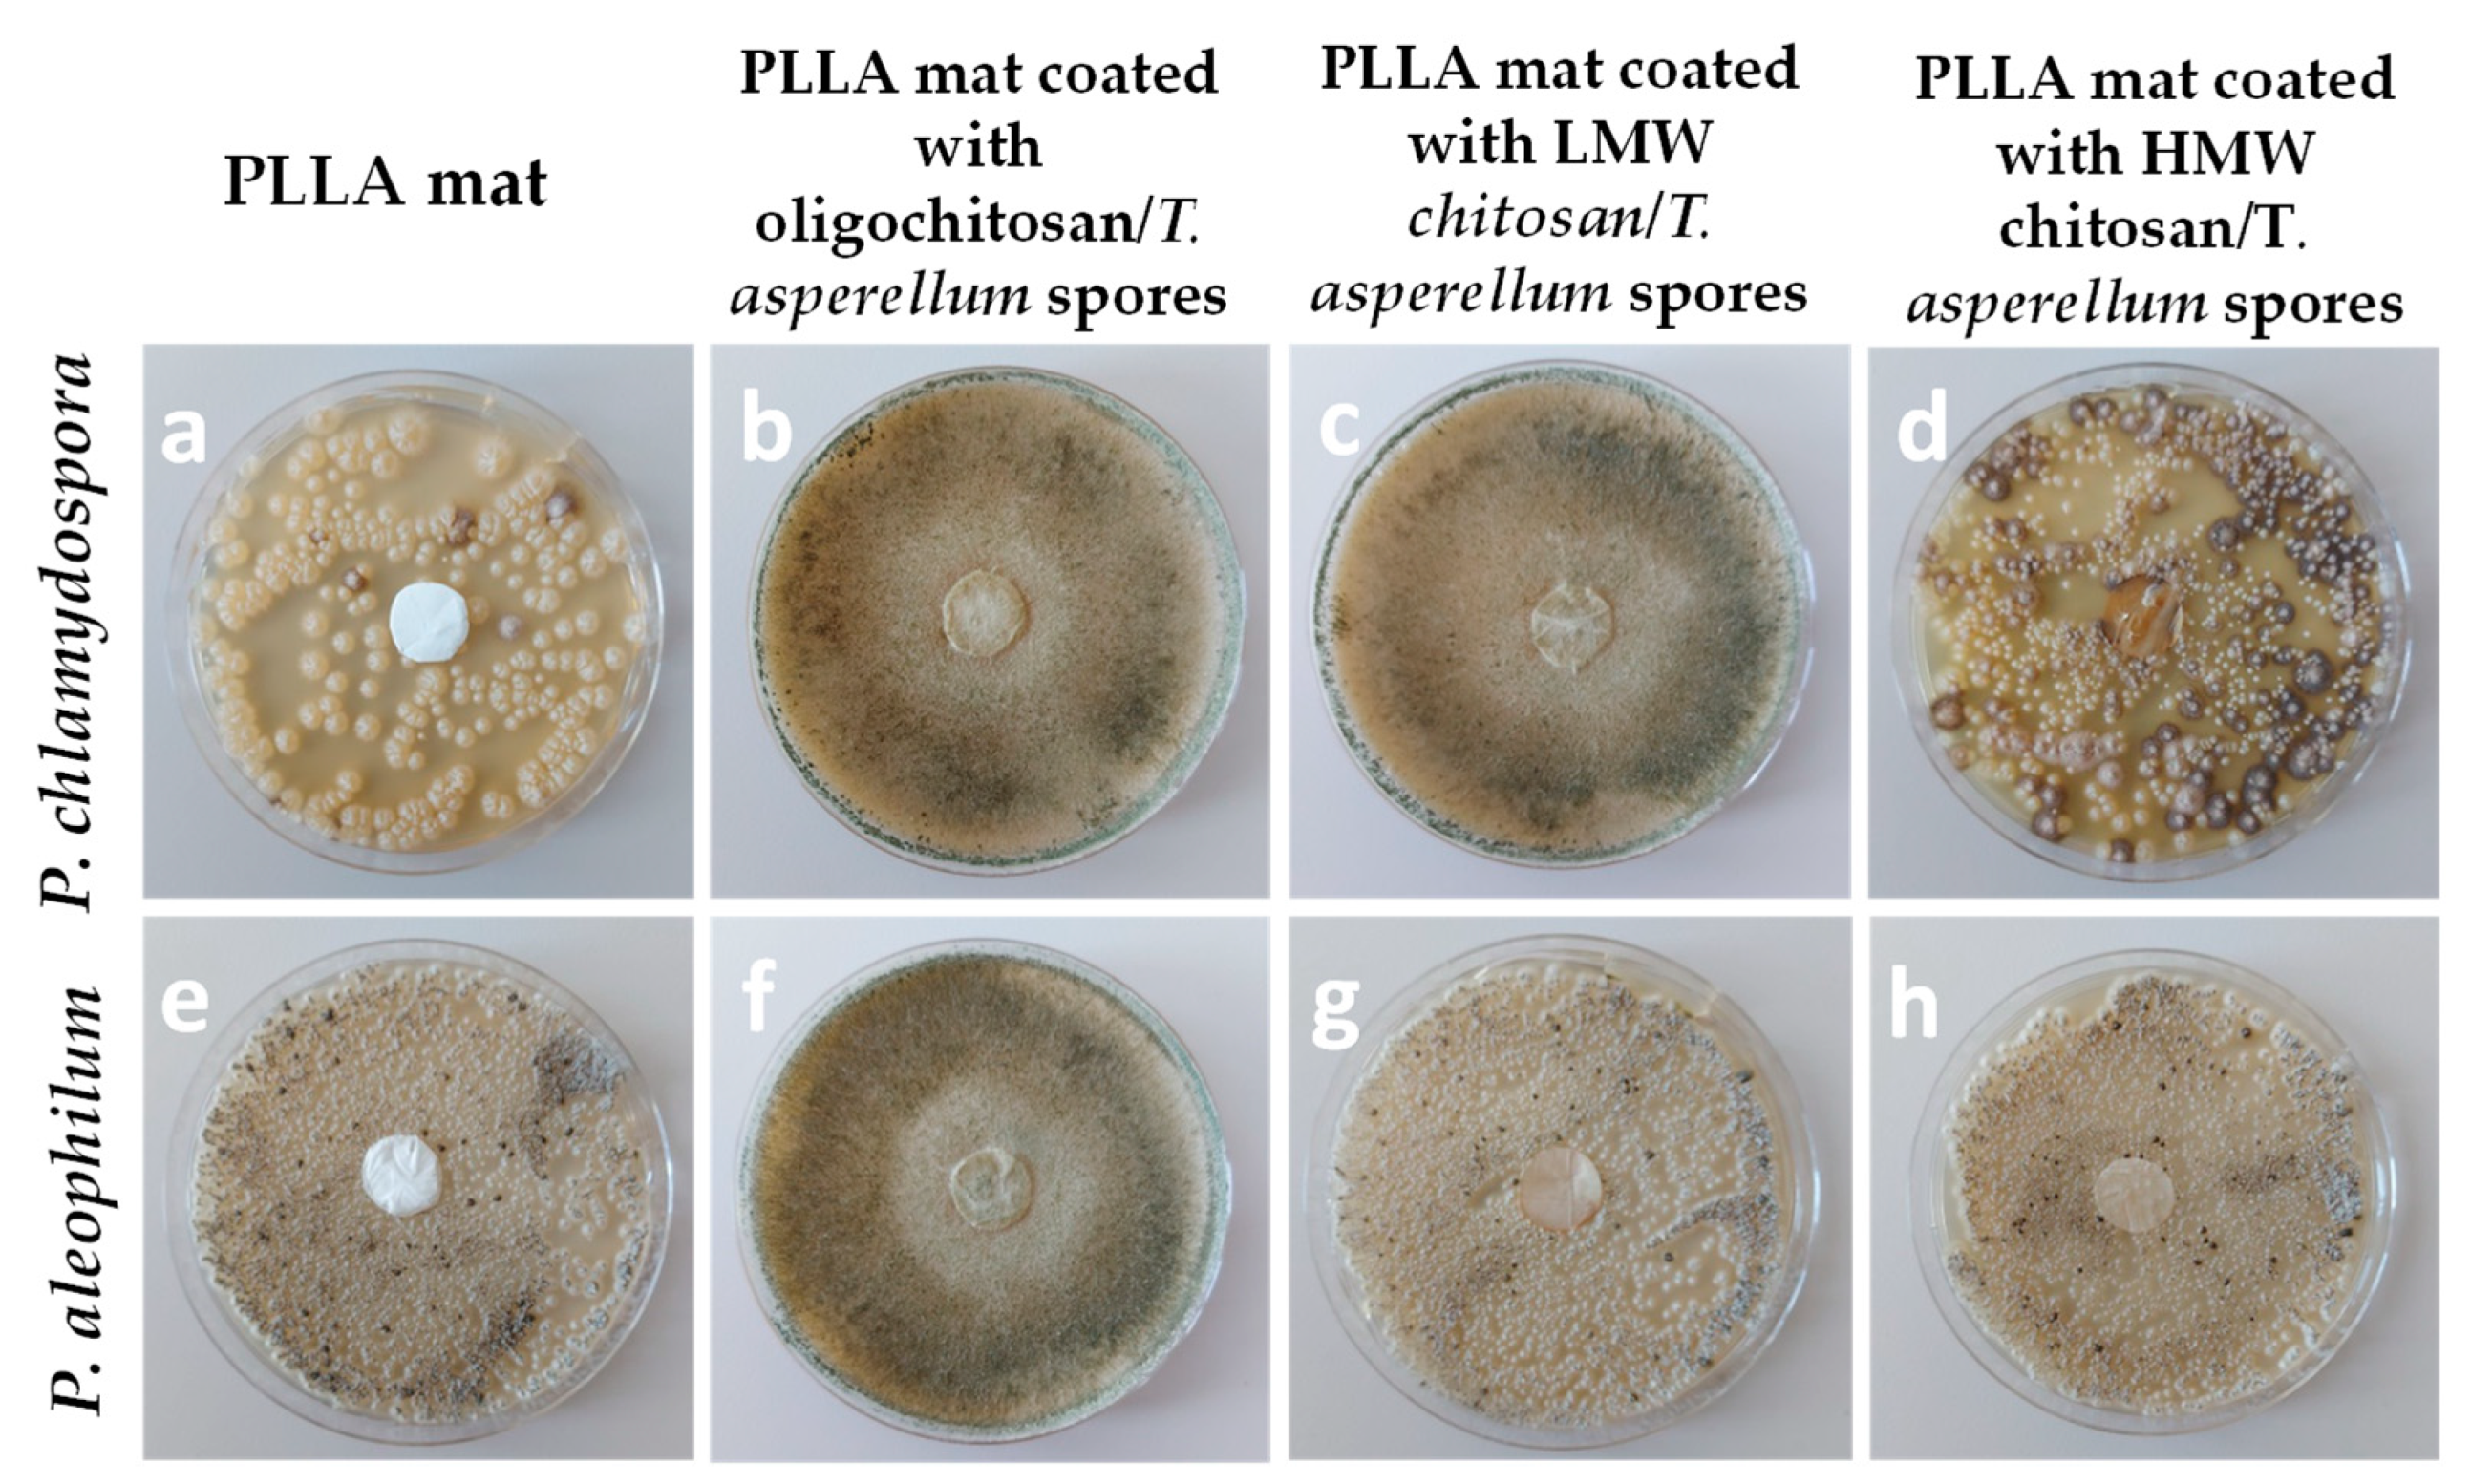
Molecules 27 05738 g008

Electrospun Polymer Materials with Fungicidal Activity: A Review
Abstract
:1. Introduction
2. Crop Diseases Caused by Fungi
3. Electrospinning
Applications
4. Electrospun Fibrous Materials with Antifungal Activity against Esca Disease
5. Future Outlook
6. Conclusions
Author Contributions
Funding
Institutional Review Board Statement
Informed Consent Statement
Data Availability Statement
Acknowledgments
Conflicts of Interest
References
- Bajakova, J.; Chaloupek, J.; Lukas, D.; Lacarin, M. “Drawing”—The production of individual nanofibers by experimental method. Nanotechnology 2020, 9, 21–23. [Google Scholar]
- Xu, T.-C.; Han, D.-H.; Zhu, Y.-M.; Duan, G.-G.; Liu, K.-M.; Hou, H.-Q. High Strength Electrospun Single Copolyacrylonitrile (coPAN) Nanofibers with Improved Molecular Orientation by Drawing. Chin. J. Polym. Sci. 2020, 39, 174–180. [Google Scholar] [CrossRef]
- Liu, S.; Shan, H.; Xia, S.; Yan, J.; Yu, J.; Ding, B. Polymer Template Synthesis of Flexible SiO2 Nanofibers to Upgrade Composite Electrolytes. ACS Appl. Mater. Interfaces 2020, 12, 31439–31447. [Google Scholar] [CrossRef]
- Song, X.; Song, Y.; Wang, J.; Liu, Q.; Duan, Z. Insights into the pore-forming effect of polyvinyl butyral (PVB) as the polymer template to synthesize mesoporous alumina nanofibers via electrospinning. Ceram. Int. 2019, 46, 9952–9956. [Google Scholar] [CrossRef]
- Yan, J.; Han, Y.; Xia, S.; Wang, X.; Zhang, Y.; Yu, J.; Ding, B. Polymer Template Synthesis of Flexible BaTiO 3 Crystal Nanofibers. Adv. Funct. Mater. 2019, 29, 1907919. [Google Scholar] [CrossRef]
- Zhao, J.; Han, W.; Chen, H.; Tu, M.; Zeng, R.; Shi, Y.; Cha, Z.; Zhou, C. Preparation, structure and crystallinity of chitosan nano-fibers by a solid–liquid phase separation technique. Carbohydr. Polym. 2011, 83, 1541–1546. [Google Scholar] [CrossRef]
- Rolandi, M.; Rolandi, R. Self-assembled chitin nanofibers and applications. Adv. Colloid Interface Sci. 2014, 207, 216–222. [Google Scholar] [CrossRef]
- Mi, H.-Y.; Jing, X.; Napiwocki, B.N.; Li, Z.-T.; Turng, L.-S.; Huang, H.-X. Fabrication of fibrous silica sponges by self-assembly electrospinning and their application in tissue engineering for three-dimensional tissue regeneration. Chem. Eng. J. 2018, 331, 652–662. [Google Scholar] [CrossRef]
- Wang, J.; Langhe, D.; Ponting, M.; Wnek, G.E.; Korley, L.T.; Baer, E. Manufacturing of polymer continuous nanofibers using a novel co-extrusion and multiplication technique. Polymer 2014, 55, 673–685. [Google Scholar] [CrossRef]
- Teo, W.E.; Ramakrishna, S. A review on electrospinning design and nanofibre assemblies. Nanotechnology 2006, 17, R89–R106. [Google Scholar] [CrossRef]
- Subrahmanya, T.; Arshad, A.; Lin, P.; Widakdo, J.; Hanumanthappa, M.; Faye, H. A review of recent progress in polymeric electrospun nanofiber membranes in addressing safe water global issues. RSC Adv. 2021, 11, 9638–9663. [Google Scholar]
- Baghali, M.; Jayathilaka, W.; Ramakrishna, S. The Role of Electrospun Nanomaterials in the Future of Energy and Environment. Materials 2021, 14, 558. [Google Scholar] [CrossRef]
- Yakub, G.; Ignatova, M.; Manolova, N.; Rashkov, I.; Toshkova, R.; Georgieva, A.; Markova, N. Chitosan/ferulic acid-coated poly(ε-caprolactone) electrospun materials with antioxidant, antibacterial and antitumor properties. Int. J. Biol. Macromol. 2018, 107, 689–702. [Google Scholar] [CrossRef]
- Iriti, M.; Faoro, F. Ancient plant diseases in Roman Age. Acta Phytopathol. et Èntomol. Hung. 2008, 43, 15–21. [Google Scholar] [CrossRef]
- Rançon, F.; Bombrun, L.; Keresztes, B.; Germain, C. Comparison of SIFT encoded and ceep learning features for the classification and detection of Esca disease in Bordeaux vineyards. Remote Sens. 2019, 11, 1. [Google Scholar] [CrossRef]
- Mugnai, L.; Graniti, A.; Surico, G. Esca (Black Measles) and Brown Wood-Streaking: Two Old and Elusive Diseases of Grapevines. Plant Dis. 1999, 83, 404–418. [Google Scholar] [CrossRef]
- Quaglia, M.; Covarelli, L.; Zazzerini, A. Epidemiological survey on esca disease in Umbria, central Italy. Phytopathol. Mediterr. 2009, 48, 84–91. [Google Scholar]
- Fischer, M.; Kassemeyer, H.-H. Fungi associated with Esca disease of grapevine in Germany. Vitis 2003, 42, 109–116. [Google Scholar]
- Surico, G.; Marchi, G.; Braccini, P.; Mugnai, L. Epidemiology of Esca in Some Vineyards in Tuscany (Italy). Phytopathol. Mediterr. 2000, 39, 190–205. [Google Scholar] [CrossRef]
- Larignon, P.; Dubos, B. Fungi associated with esca disease in grapevine. Eur. J. Plant Pathol. 1997, 103, 147–157. [Google Scholar] [CrossRef]
- Crous, P.W.; Gams, W. Phaeomoniella chlamydospora Gen. et Comb. Nov., a Causal Organism of Petri Grapevine Decline and Esca. Phytopathol. Mediterr. 2000, 39, 112–118. [Google Scholar] [CrossRef]
- Bertsch, C.; Ramírez-Suero, M.; Magninrobert, M.; Larignon, P.; Chong, J.; Abou-Mansour, E.; Spagnolo, A.; Clément, C.; Fontaine, F. Grapevine trunk diseases: Complex and still poorly understood. Plant Pathol. 2013, 62, 243–265. [Google Scholar] [CrossRef]
- Hofstetter, V.; Buyck, B.; Croll, D.; Viret, O.; Couloux, A.; Gindro, K. What if esca disease of grapevine were not a fungal disease? Fungal Divers. 2012, 54, 51–67. [Google Scholar] [CrossRef]
- Sikder, A.; Pearce, A.; Parkinson, S.; Napier, R.; O’Reilly, R. Recent trends in advanced polymer materials in agriculture related applications. ACS Appl. Polym. Mater. 2021, 3, 1203–1217. [Google Scholar] [CrossRef]
- Noruzi, M. Electrospun nanofibres in agriculture and the food industry: A review. J. Sci. Food Agric. 2016, 96, 4663–4678. [Google Scholar] [CrossRef]
- Larignon, P. Les maladies du bois en Midi-Pyrénées Esca et BDA. La constitution d’un groupe international de travail sur les maladies du bois et les premiers résultats des expérimentations menées par l’ITV en laboratoire et en pépinières. Progrès Agric. Et Vitic. 2005, 5, 103–106. [Google Scholar]
- Cooley, J. Apparatus for Electrically Dispersing Fluids. US Patent 692,631, 4 February 1902. [Google Scholar]
- Zeleny, J. The Electrical Discharge from Liquid Points, and a Hydrostatic Method of Measuring the Electric Intensity at Their Surfaces. Phys. Rev. 1914, 3, 69–91. [Google Scholar] [CrossRef]
- Formhals, A. Process and Apparatus for Preparing Artificial Threads. US Patent No. 1975504, 2 October 1934. [Google Scholar]
- Taylor, G. Electrically driven jets. Proc. R. Soc. Lond. A 1969, 313, 453–475. [Google Scholar]
- Dziemidowicz, K.; Sang, Q.; Wu, J.; Zhang, Z.; Zhou, F.; Lagaron, J.M.; Mo, X.-M.; Parker, G.J.M.; Yu, D.-G.; Zhu, L.-M.; et al. Electrospinning for healthcare: Recent advancements. J. Mater. Chem. B 2020, 9, 939–951. [Google Scholar] [CrossRef]
- Shenoy, S.L.; Bates, W.D.; Frisch, H.L.; Wnek, G.E. Role of chain entanglements on fiber formation during electrospinning of polymer solutions: Good solvent, non-specific polymer–polymer interaction limit. Polymer 2005, 46, 3372–3384. [Google Scholar] [CrossRef]
- Zgenghua, L.; Jing, W.; Haiying, D.; Huisheng, W.; Xiaogan, L.; Xiaofeng, W. Joint simulation of electrospinning trajectory. Chin. J. Mater. Res. 2018, 32, 127–135. [Google Scholar]
- Tarus, B.; Fadel, N.; Al-Oufy, A.; El-Messiry, M. Effect of polymer concentration on the morphology and mechanical characteristics of electrospun cellulose acetate and poly (vinyl chloride) nanofiber mats. Alex. Eng. J. 2016, 55, 2975–2984. [Google Scholar] [CrossRef]
- Bhardaj, N.; Kundu, S. Electrospinning: A fascinating fiber fabrication technique. Biotechnol. Adv. 2010, 28, 325–347. [Google Scholar] [CrossRef] [PubMed]
- Taylor, G.I. Disintegration of water drops in an electric field. Proc. R. Soc. London. Ser. A 1964, 280, 383–397. [Google Scholar] [CrossRef]
- Megelski, S.; Stephens, J.S.; Chase, A.D.B.; Rabolt, J.F. Micro- and Nanostructured Surface Morphology on Electrospun Polymer Fibers. Macromolecules 2002, 35, 8456–8466. [Google Scholar] [CrossRef]
- Lee, J.S.; Choi, K.H.; Ghim, H.D.; Kim, S.S.; Chun, D.H.; Kim, H.Y.; Lyoo, W.S. Role of molecular weight of atactic poly(vinyl alcohol) (PVA) in the structure and properties of PVA nanofabric prepared by electrospinning. J. Appl. Polym. Sci. 2004, 93, 1638–1646. [Google Scholar] [CrossRef]
- Geng, X.; Kwon, O.-H.; Jang, J. Electrospinning of chitosan dissolved in concentrated acetic acid solution. Biomaterials 2005, 26, 5427–5432. [Google Scholar] [CrossRef]
- Mit-Uppatham, C.; Nithitanakul, M.; Supaphol, P. Ultrafine Electrospun Polyamide-6 Fibers: Effect of Solution Conditions on Morphology and Average Fiber Diameter. Macromol. Chem. Phys. 2004, 205, 2327–2338. [Google Scholar] [CrossRef]
- Rashkov, I.; Stoilova, O.; Manolova, N. Multifunctional Rotating Drum Collector for Electrospinning Set-Up. Patent 67365, 27 July 2021. [Google Scholar]
- Toncheva, A.; Spasova, M.; Paneva, D.; Manolova, N.; Rashkov, I. Drug-loaded electrospun polylactide bundles. J. Bioact. Compat. Polym. 2011, 26, 161–172. [Google Scholar] [CrossRef]
- Gibson, P.; Schreuder-Gibson, H.; Rivin, D. Transport properties of porous membranes based on electrospun nanofibers. Colloids Surf. A Physicochem. Eng. Asp. 2001, 187–188, 469–481. [Google Scholar] [CrossRef]
- Liu, Q.; Chen, Z.; Pei, X.; Guo, C.; Teng, K.; Hu, Y.; Xu, Z.; Qian, X. Review: Applications, effects and the prospects for electrospun nanofibrous mats in membrane separation. J. Mater. Sci. 2019, 55, 893–924. [Google Scholar] [CrossRef]
- Kaur, S.; Sundarrajan, S.; Rana, D.; Sridhar, R.; Gopal, R.; Matsuura, T.; Ramakrishna, S. Review: The characterization of electrospun nanofibrous liquid filtration membranes. J. Mater. Sci. 2014, 49, 6143–6159. [Google Scholar] [CrossRef]
- Chen, Z.; Song, Y.; Zhang, J.; Liu, W.; Cui, J.; Li, H.; Chen, F. Laminated electrospun nHA/PHB-composite scaffolds mimicking bone extracellular matrix for bone tissue engineering. Mater. Sci. Eng. C 2017, 72, 341–351. [Google Scholar] [CrossRef]
- Gautam, S.; Dinda, A.K.; Mishra, N.C. Fabrication and characterization of PCL/gelatin composite nanofibrous scaffold for tissue engineering applications by electrospinning method. Mater. Sci. Eng. C 2013, 33, 1228–1235. [Google Scholar] [CrossRef] [PubMed]
- Khoshnevisan, K.; Maleki, H.; Samadian, H.; Shahsavari, S.; Sarrafzadeh, M.H.; Larijani, B.; Dorkoosh, F.A.; Haghpanah, V.; Khorramizadeh, M.R. Cellulose acetate electrospun nanofibers for drug delivery systems: Applications and recent advances. Carbohydr. Polym. 2018, 198, 131–141. [Google Scholar] [CrossRef]
- Yar, M.; Farooq, A.; Shahzadi, L.; Khan, A.S.; Mahmood, N.; Rauf, A.; Chaudhry, A.A.; Rehman, I.U. Novel meloxicam releasing electrospun polymer/ceramic reinforced biodegradable membranes for periodontal regeneration applications. Mater. Sci. Eng. C 2016, 64, 148–156. [Google Scholar] [CrossRef]
- Faccini, M.; Vaquero, C.; Amantia, D. Development of Protective Clothing against Nanoparticle Based on Electrospun Nanofibers. J. Nanomater. 2012, 2012, 892894. [Google Scholar] [CrossRef] [Green Version]
- Chen, K.; Chou, W.; Liu, L.; Cui, Y.; Xue, P.; Jia, M. Electrochemical Sensors Fabricated by Electrospinning Technology: An Overview. Sensors 2019, 19, 3676. [Google Scholar] [CrossRef]
- Wei, Q.; Deng, N.-N.; Guo, J.; Deng, J. Synthetic Polymers for Biomedical Applications. Int. J. Biomater. 2018, 2018, 7158621. [Google Scholar] [CrossRef]
- Sung, Y.K.; Kim, S.W. Recent advances in polymeric drug delivery systems. Biomater. Res. 2020, 24, 12. [Google Scholar] [CrossRef]
- Behravesh, E.; Yasko, A.W.; Engel, P.S.; Mikos, A.G. Synthetic Biodegradable Polymers for Orthopaedic Applications. Clin. Orthop. Relat. Res. 1999, 367, S118–S129. [Google Scholar] [CrossRef] [PubMed]
- Middleton, J.C.; Tipton, A.J. Synthetic biodegradable polymers as orthopedic devices. Biomaterials 2000, 21, 2335–2346. [Google Scholar] [CrossRef]
- Fattahi, F.S.; Khoddami, A.; Avinc, O. Poly(lactic acid) (PLA) Nanofibers for Bone Tissue Engineering. J. Text. Polym. 2019, 7, 47–64. [Google Scholar]
- Gangolphe, L.; Leon-Valdivieso, C.Y.; Nottelet, B.; Déjean, S.; Bethry, A.; Pinese, C.; Bossard, F.; Garric, X. Electrospun microstructured PLA-based scaffolds featuring relevant anisotropic, mechanical and degradation characteristics for soft tissue engineering. Mater. Sci. Eng. C 2021, 129, 112339. [Google Scholar] [CrossRef] [PubMed]
- Magiera, A.; Markowski, J.; Menaszek, E.; Pilch, J.; Blazewicz, S. PLA-Based Hybrid and Composite Electrospun Fibrous Scaffolds as Potential Materials for Tissue Engineering. J. Nanomater. 2017, 2017, 9246802. [Google Scholar] [CrossRef]
- DeStefano, V.; Khan, S.; Tabada, A. Applications of PLA in modern medicine. Eng. Regen. 2020, 1, 76–87. [Google Scholar] [CrossRef]
- Gutiérrez-Sánchez, M.; Escobar-Barrios, V.A.; Pozos-Guillén, A.; Escobar-García, D.M. RGD-functionalization of PLA/starch scaffolds obtained by electrospinning and evaluated in vitro for potential bone regeneration. Mater. Sci. Eng. C 2019, 96, 798–806. [Google Scholar] [CrossRef]
- Dai, X.; Li, X.; Zhang, M.; Xie, J.; Wang, X. Zeolitic Imidazole Framework/Graphene Oxide Hybrid Functionalized Poly(lactic acid) Electrospun Membranes: A Promising Environmentally Friendly Water Treatment Material. ACS Omega 2018, 3, 6860–6866. [Google Scholar] [CrossRef] [Green Version]
- Spasova, M.; Stoilova, O.; Manolova, N.; Rashkov, I.; Altankov, G. Preparation of PLLA/PEG Nanofibers by Electrospinning and Potential Applications. J. Bioact. Compat. Polym. 2007, 22, 62–76. [Google Scholar] [CrossRef]
- Spasova, M.; Paneva, D.; Manolova, N.; Radenkov, P.; Rashkov, I. Electrospun chitosan-coated fibers of poly(L-lactide) and poly(L-lactide)/poly(ethylene glycol): Preparation and characterization. Macromol. Biosci. 2008, 8, 153–162. [Google Scholar] [CrossRef]
- Ignatova, M.; Manolova, N.; Markova, N.; Rashkov, I. Electrospun Non-Woven Nanofibrous Hybrid Mats Based on Chitosan and PLA for Wound-Dressing Applications. Macromol. Biosci. 2009, 9, 102–111. [Google Scholar] [CrossRef] [PubMed]
- Toncheva, A.; Paneva, D.; Manolova, N.; Rashkov, I. Electrospun poly(L-lactide) membranes containing a single drug or multiple drug system for antimicrobial wound dressings. Macromol. Res. 2011, 19, 1310–1319. [Google Scholar] [CrossRef]
- Ignatova, M.; Stoyanova, N.; Manolova, N.; Rashkov, I.; Kukeva, R.; Stoyanova, R.; Toshkova, R.; Georgieva, A. Electrospun materials from polylactide and Schiff base derivative of Jeffamine ED® and 8-hydroxyquinoline-2-carboxaldehyde and its complex with Cu2+: Preparation, antioxidant and antitumor activities. Mater. Sci. Eng. C 2020, 116, 111185. [Google Scholar] [CrossRef] [PubMed]
- Toncheva, A.; Paneva, D.; Manolova, N.; Rashkov, I.; Mita, L.; Crispi, S.; Damiano, G.M. Dual vs. single spinneret electrospinning for the preparation of dual drug containing non-woven fibrous materials. Colloids Surfaces A: Physicochem. Eng. Asp. 2013, 439, 176–183. [Google Scholar] [CrossRef]
- Toncheva, A.; Spasova, M.; Paneva, D.; Manolova, N.; Rashkov, I. Polylactide (PLA)-based electrospun fibrous materials containing ionic drugs as wound dressing materials: A review. Int. J. Polym. Mater. Polym. Biomater. 2014, 63, 657–671. [Google Scholar] [CrossRef]
- Virovska, D.; Paneva, D.; Manolova, N.; Rashkov, I.; Karashanova, D. Electrospinning/electrospraying vs. electrospinning: A comparative study on the design of poly(l-lactide)/zinc oxide non-woven textile. Appl. Surf. Sci. 2014, 311, 842–850. [Google Scholar] [CrossRef]
- Virovska, D.; Paneva, D.; Manolova, N.; Rashkov, I.; Karashanova, D. Photocatalytic self-cleaning poly(l-lactide) materials based on a hybrid between nanosized zinc oxide and expanded graphite or fullerene. Mater. Sci. Eng. C 2016, 60, 184–194. [Google Scholar] [CrossRef]
- Vallianou, N.G.; Evangelopoulos, A.; Schizas, N.; Kazazis, C. Potential anticancer properties and mechanisms of action of curcumin. Anticancer Res. 2015, 35, 645–652. [Google Scholar]
- Perrone, D.; Ardito, F.; Giannatempo, G.; Dioguardi, M.; Troiano, G.; Russo, L.; Lillo, A.; Laino, L.; Muzio, L. Biological and therapeutic activities, and anticancer properties of curcumin (Review). Exp. Ther. Med. 2015, 10, 1615–1623. [Google Scholar] [CrossRef] [Green Version]
- Yakub, G.; Toncheva, A.; Manolova, N.; Rashkov, I.; Kussovski, V.; Danchev, D. Curcumin-loaded poly(l-lactide-co-D,l-lactide) electrospun fibers: Preparation and antioxidant, anticoagulant, and antibacterial properties. J. Bioact. Compat. Polym. 2014, 29, 607–627. [Google Scholar] [CrossRef]
- Yakub, G.; Toncheva, A.; Manolova, N.; Rashkov, I.; Danchev, D.; Kussovski, V. Electrospun polylactide-based materials for curcumin release: Photostability, antimicrobial activity, and anticoagulant effect. J. Appl. Polym. Sci. 2015, 133, 42940. [Google Scholar] [CrossRef]
- Spasova, M.; Mespouille, L.; Coulembier, O.; Paneva, D.; Manolova, N.; Rashkov, I.; Dubois, P. amphiphilic poly(d- or l-lactide)-b-poly(N,N-dimethylamino-2-ethyl methacrylate) block copolymers: Controlled synthesis, characterization, and stereocomplex formation. Biomacromolecules 2009, 10, 1217–1223. [Google Scholar] [CrossRef] [PubMed]
- Spasova, M.; Manolova, N.; Paneva, D.; Mincheva, R.; Dubois, P.; Rashkov, I.; Maximova, V.; Danchev, D. Polylactide Stereocomplex-Based Electrospun Materials Possessing Surface with Antibacterial and Hemostatic Properties. Biomacromolecules 2010, 11, 151–159. [Google Scholar] [CrossRef] [PubMed]
- Stoyanova, N.; Mincheva, R.; Paneva, D.; Manolova, N.; Dubois, P.; Rashkov, I. Electrospun non-woven mats from stereocomplex between high molar mass poly(l-lactide) and poly(d-lactide)-block-poly(butylene succinate) copoly(ester urethane)s. Eur. Polym. J. 2012, 48, 1965–1975. [Google Scholar] [CrossRef]
- Paneva, D.; Spasova, M.; Stoyanova, N.; Manolova, N.; Rashkov, I. Electrospun fibers from polylactide-based stereocomplex: Why? Int. J. Polym. Mater. Polym. Biomater. 2019, 70, 270–286. [Google Scholar] [CrossRef]
- Yancheva, E.; Paneva, D.; Manolova, N.; Mincheva, R.; Danchev, D.; Dubois, P.; Rashkov, I. Tuning of the Surface Biological Behavior of Poly(l-lactide)-Based Electrospun Materials by Polyelectrolyte Complex Formation. Biomacromolecules 2010, 11, 521–532. [Google Scholar] [CrossRef]
- Jatoi, A.W.; Kim, I.S.; Ni, Q.-Q. Cellulose acetate nanofibers embedded with AgNPs anchored TiO2 nanoparticles for long term excellent antibacterial applications. Carbohydr. Polym. 2019, 207, 640–649. [Google Scholar] [CrossRef]
- Spasova, M.; Manolova, N.; Markova, N.; Rashkov, I. Tuning the properties of PVDF or PVDF-HFP fibrous materials decorated with ZnO nanoparticles by applying electrospinning alone or in conjunction with electrospraying. Fibers Polym. 2017, 18, 649–657. [Google Scholar] [CrossRef]
- Wen, P.; Min-Hua, Z.; Robert, L.; Kun, F.; Hong, W. Electrospinning: A novel nano-encapsulation approach for bioactive compounds. Trends Food Sci. Technol. 2017, 70, 56–68. [Google Scholar] [CrossRef]
- Meraz-Dávila, S.; Garcia, C.E.P.; Feregrino-Perez, A.A. Challenges and advantages of electrospun nanofibers in agriculture: A review. Mater. Res. Express 2021, 8, 042001. [Google Scholar] [CrossRef]
- Sapountzi, E.; Braiek, M.; Chateaux, J.-F.; Jaffrezic-Renault, N.; Lagarde, F. Recent Advances in Electrospun Nanofiber Interfaces for Biosensing Devices. Sensors 2017, 17, 1887. [Google Scholar] [CrossRef] [PubMed]
- Liu, Y.; Ming, H.; Chen, Z.; Liu, L.; Liu, Y.; Yang, W.; Ramakrishna, S. A review on recent advances in application of electrospun nanofiber materials as biosensors. Curr. Opin. Biomed. Eng. 2020, 13, 174–189. [Google Scholar] [CrossRef]
- Lee, S.; Obendorf, K. Developing protective textile materials as barriers to liquid penetration using melt-electrospinning. J. Appl. Polym. Sci. 2006, 102, 3430–3437. [Google Scholar] [CrossRef]
- Hemmati, F.; Bahrami, A.; Esfanjani, A.F.; Hosseini, H.; McClements, D.J.; Williams, L. Electrospun antimicrobial materials: Advanced packaging materials for food applications. Trends Food Sci. Technol. 2021, 111, 520–533. [Google Scholar] [CrossRef]
- Kumar, T.S.M.; Kumar, K.S.; Rajini, N.; Siengchin, S.; Ayrilmis, N.; Rajulu, A.V. A comprehensive review of electrospun nanofibers: Food and packaging perspective. Compos. Part B Eng. 2019, 175, 107074. [Google Scholar] [CrossRef]
- Sett, S.; Lee, M.W.; Weith, M.; Pourdeyhimi, B.; Yarin, A.L. Biodegradable and biocompatible soy protein/polymer/adhesive sticky nano-textured interfacial membranes for prevention of esca fungi invasion into pruning cuts and wounds of vines. J. Mater. Chem. B 2015, 3, 2147–2162. [Google Scholar] [CrossRef]
- Buchholz, V.; Molnar, M.; Wang, H.; Reich, S.; Agarwal, S.; Fischer, M.; Greiner, A. Protection of Vine Plants against Esca Disease by Breathable Electrospun Antifungal Nonwovens. Macromol. Biosci. 2016, 16, 1391–1397. [Google Scholar] [CrossRef]
- Song, Y.; Xu, H.; Chen, W.; Zhan, P.; Liu, X. 8-Hydroxyquinoline: A privileged structure with a broad-ranging pharmacological potential. MedChemComm 2015, 6, 61–74. [Google Scholar] [CrossRef]
- Bankova, M.; Manolova, N.; Markova, N.; Radoucheva, T.; Dilova, I.; Rashkov, I. Copolymers of 5-chloro-7-quinolinyl acrylate and acrylamide: Synthesis, hydrolysis, behaviour and antibacterial activity. Eur. Polym. J. 1997, 34, 247–253. [Google Scholar]
- de la Guardia, C.; Stephens, D.E.; Dang, H.T.; Quijada, M.; Larionov, O.V.; Lleonart, R. Antiviral Activity of Novel Quinoline Derivatives against Dengue Virus Serotype 2. Molecules 2018, 23, 672. [Google Scholar] [CrossRef] [Green Version]
- Tanzer, J.M.; Slee, A.M.; Kamay, B.; Scheer, E. Activity of Three 8-Hydroxyquinoline Derivatives Against In Vitro Dental Plaque. Antimicrob. Agents Chemother. 1978, 13, 1044–1045. [Google Scholar] [CrossRef] [PubMed]
- Gupta, R.; Luxami, V.; Paul, K. Insights of 8-hydroxyquinolines: A novel target in medicinal chemistry. Bioorg. Chem. 2021, 108, 104633. [Google Scholar] [CrossRef] [PubMed]
- Spasova, M.; Manolova, N.; Rashkov, I. Composition of Plant Protection Product. Utility Model BG3265U1, 10 September 2019. [Google Scholar]
- Spasova, M.; Manolova, N.; Rashkov, I.; Naydenov, M. Electrospun 5-chloro-8-hydroxyquinoline-Loaded Cellulose Acetate/Polyethylene Glycol Antifungal Membranes Against Esca. Polymers 2019, 11, 1617. [Google Scholar] [CrossRef]
- Nachev, N.; Spasova, M.; Tsekova, P.; Manolova, N.; Rashkov, I.; Naydenov, M. Electrospun Polymer-Fungicide Nanocomposites for Grapevine Protection. Polymers 2021, 13, 3673. [Google Scholar] [CrossRef]
- Ignatova, M.; Nachev, N.; Spasova, M.; Manolova, N.; Rashkov, I.; Naydenov, M. Electrospun 5-chloro-7-iodo-8-hydroxyquinoline (Clioquinol)-containing poly(3-hydroxybutyrate)/polyvinylpyrrolidone antifungal materials prospective as active dressings against esca. Polymers 2022, 14, 367. [Google Scholar] [CrossRef] [PubMed]
- Kumar, K.; Ghosh, P.; Kumar, A. Improving mechanical and thermal properties of TiO2-epoxy nanocomposite. Compos. Part B Eng. 2016, 97, 353–360. [Google Scholar] [CrossRef]
- Al-Mohaimeed, A.M.; Al-Onazi, W.A.; El-Tohamy, M.F. Multifunctional Eco-Friendly Synthesis of ZnO Nanoparticles in Biomedical Applications. Molecules 2022, 27, 579. [Google Scholar] [CrossRef]
- Shibata, H.; Ogura, Y.; Sawa, Y.; Kono, Y. Hydroxyl Radical Generation Depending on O2 or H2O by a Photocatalyzed Reaction in an Aqueous Suspension of Titanium Dioxide. Biosci. Biotechnol. Biochem. 1998, 62, 2306–2311. [Google Scholar] [CrossRef] [PubMed]
- Abdullah, A.M.; Garcia-Pinilla, M.; Pillai, S.C.; O’Shea, K. UV and Visible Light-Driven Production of Hydroxyl Radicals by Reduced Forms of N, F, and P Codoped Titanium Dioxide. Molecules 2019, 24, 2147. [Google Scholar] [CrossRef]
- Xu, X.; Chen, D.; Yi, Z.; Jiang, M.; Wang, L.; Zhou, Z.; Fan, X.; Wang, Y.; Hui, D. Antimicrobial mechanism based on H2O2 generation at oxygen vacancies in ZnO crystals. Langmuir 2013, 29, 5573–5580. [Google Scholar] [CrossRef]
- Farzana, R.; Iqra, P.; Shafaq, F.; Sumaira, S.; Zakia, K.; Hunaiza, T.; Husna, M. Antimicrobial behavior of zinc oxide nanoparticles and β-lactam antibiotics against pathogenic bacteria. Arch. Clin. Microbiol. 2017, 8, 57. [Google Scholar]
- Korina, E.; Stoilova, O.; Manolova, N.; Rashkov, I. Multifunctional Hybrid Materials from Poly(3-Hydroxybutyrate), TiO2 Nanoparticles, and Chitosan Oligomers by Combining Electrospinning/Electrospraying and Impregnation. Macromol. Biosci. 2013, 13, 707–716. [Google Scholar] [CrossRef] [PubMed]
- Korina, E.; Stoilova, O.; Manolova, N.; Rashkov, I. Poly(3-hydroxybutyrate)-based hybrid materials with photocatalytic and magnetic properties prepared by electrospinning and electrospraying. J. Mater. Sci. 2014, 49, 2144–2153. [Google Scholar] [CrossRef]
- Spasova, M.; Stoilova, O.; Manolova, N.; Rashkov, I.; Naydenov, M. Electrospun Eco-Friendly Materials Based on Poly(3-hydroxybutyrate) (PHB) and TiO2 with Antifungal Activity Prospective for Esca Treatment. Polymers 2020, 12, 1384. [Google Scholar] [CrossRef] [PubMed]
- Nachev, N.; Spasova, M.; Manolova, N.; Rashkov, I.; Naydenov, M. Improving the Water-Repellent and Antifungal Properties of Electrospun Cellulose Acetate Materials by Decoration with ZnO Nanoparticles. Fibres Text. East. Eur. 2021, 29, 40–45. [Google Scholar] [CrossRef]
- Fenton, D.M.; Eveleigh, D.E. Purification and Mode of Action of a Chitosanase from Penicillium islandicum. Microbiology 1981, 126, 151–165. [Google Scholar] [CrossRef]
- Nogawa, M.; Takahashi, H.; Kashiwagi, A.; Ohshima, K.; Okada, H.; Morikawa, Y. Purification and Characterization of Exo-β- d -Glucosaminidase from a Cellulolytic Fungus, Trichoderma reesei PC-3-7. Appl. Environ. Microbiol. 1998, 64, 890–895. [Google Scholar] [CrossRef]
- Ilyina, A.V.; Tatarinova, N.Y.; Varlamov, V.P. The preparation of low-molecular-weight chitosan using chitinolytic complex from Streptomyces kurssanovii. Process Biochem. 1999, 34, 875–878. [Google Scholar] [CrossRef]
- Kurakake, M.; Yo-U, S.; Nakagawa, K.; Sugihara, M.; Komaki, T. Properties of Chitosanase from Bacillus cereus S1. Curr. Microbiol. 2000, 40, 6–9. [Google Scholar] [CrossRef]
- Spasova, M.; Manolova, N.; Naydenov, M.; Kuzmanova, J.; Rashkov, I. Electrospun biohybrid materials for plant biocontrol containing chitosan and Trichoderma viride spores. J. Bioact. Compat. Polym. 2011, 26, 48–55. [Google Scholar] [CrossRef]
- Spasova, M.; Manolova, N.; Rashkov, I.; Naydenov, M. Eco-Friendly Hybrid PLLA/Chitosan/Trichoderma asperellum Nanomaterials as Biocontrol Dressings against Esca Disease in Grapevines. Polymers 2022, 14, 2356. [Google Scholar] [CrossRef] [PubMed]

Publisher’s Note: MDPI stays neutral with regard to jurisdictional claims in published maps and institutional affiliations. |
© 2022 by the authors. Licensee MDPI, Basel, Switzerland. This article is an open access article distributed under the terms and conditions of the Creative Commons Attribution (CC BY) license (https://creativecommons.org/licenses/by/4.0/).
Share and Cite
Nachev, N.; Spasova, M.; Manolova, N.; Rashkov, I.; Naydenov, M. Electrospun Polymer Materials with Fungicidal Activity: A Review. Molecules 2022, 27, 5738. https://doi.org/10.3390/molecules27175738
Nachev N, Spasova M, Manolova N, Rashkov I, Naydenov M. Electrospun Polymer Materials with Fungicidal Activity: A Review. Molecules. 2022; 27(17):5738. https://doi.org/10.3390/molecules27175738
Chicago/Turabian StyleNachev, Nasko, Mariya Spasova, Nevena Manolova, Iliya Rashkov, and Mladen Naydenov. 2022. "Electrospun Polymer Materials with Fungicidal Activity: A Review" Molecules 27, no. 17: 5738. https://doi.org/10.3390/molecules27175738
APA StyleNachev, N., Spasova, M., Manolova, N., Rashkov, I., & Naydenov, M. (2022). Electrospun Polymer Materials with Fungicidal Activity: A Review. Molecules, 27(17), 5738. https://doi.org/10.3390/molecules27175738

